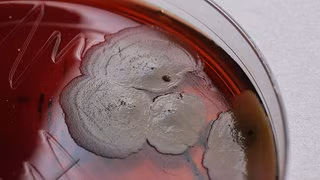
Wie Bakterien resistent gegen Antibiotika werden und was dagegen hilft

- Russland gibt Details zu Oreschnik-Raketenangriff bekannt
- CDU-Außenpolitiker für deutsche Beteiligung an europäischem Atom-Schutzschirm
- Die Ereignisse von gestern – 11. Januar 2026
- Weitere Nachrichten und Podcast zum Ukraine-Krieg
21:25 Uhr | Selenskyj: Russland bereitet heftigen Angriff vor
Der ukrainische Präsident Wolodymyr Selenskyj hat die Bürger seines Landes vor einem weiteren heftigen Angriff Russlands gewarnt. Selenskyj sagte in seiner abendlichen Videobotschaft, es gebe Geheimdienstinformationen, wonach Moskau erneut einen massiven Angriff vorbereite. Der Angriff könne in den nächsten Tagen geschehen, sagte Selenskyj. Russland wolle die Kälte ausnutzen.
Bereits am vergangenen Donnerstag hatte Selenskyj vor einem neuen massiven Angriff Moskaus in der Nacht gewarnt. Tatsächlich attackierte Russlands Militär die Ukraine in der Nacht zu Freitag heftig. In der Hauptstadt Kiew kam es in der Folge zu massiven Ausfällen von Strom-, Wasser- und Heizungsversorgung. (Quelle: DPA)
19:06 Uhr | UNO registriert mehr als 2.500 getötete Zivilisten im Jahr 2025
Im vergangenen Jahr sind in der Ukraine nach Angaben der UN-Menschenrechtsbeobachtungsmission 2.514 Zivilisten durch kriegsbedingte Gewalt getötet worden. Dies sei ein Anstieg um 31 Prozent gegenüber 2024. Die überwiegende Mehrheit der von den Beobachtern bestätigten Opfer hat es demnach in von der ukrainischen Regierung kontrollierten Gebieten durch Angriffe der russischen Streitkräfte gegeben. Fast zwei Drittel aller Opfer seien in Frontgebieten zu beklagen, wobei ältere Menschen besonders betroffen seien, da sie in ihren Dörfern geblieben seien. (Quelle: Reuters)
17:09 Uhr | Russland gibt Details zu Oreschnik-Raketenangriff bekannt
Russland hat nach eigenen Angaben bei seinem jüngsten Angriff mit einer Hyperschallrakete vom Typ Oreschnik ein Flugzeuginstandhaltungswerk in der Ukraine getroffen. Das russische Verteidigungsministerium erklärte, das Werk in Lwiw sei dabei außer Gefecht gesetzt worden. In dem Betrieb seien Flugzeuge der ukrainischen Streitkräfte repariert und gewartet worden, darunter F-16 und MiG-29. Zudem habe das Unternehmen Drohnen hergestellt, die für Angriffe auf zivile Ziele in Russlandeingesetzt würden.
Die Ukraine hatte erklärt, die Rakete habe ein ziviles Ziel getroffen. Kiew und seine europäischen Unterstützer verurteilten den Angriff vom Freitag. Es war erst der zweite bekannte Einsatz dieser ballistischen Mittelstreckenrakete, die auch mit Atomwaffen bestückt werden kann, in dem Krieg. (Quelle: Reuters, AFP)
16:58 Uhr | Rheinmetall liefert Schützenpanzer an Ukraine
Der Rüstungskonzern Rheinmetall liefert fünf Schützenpanzer an die Ukraine. Wie das Unternehmen mitteilte, sollen die ersten Fahrzeuge des Typs Lynx KF41 Anfang 2026 geliefert werden. Der Auftragswert für die fünf Fahrzeuge belaufe sich auf einen mittleren zweistelligen Millionen-Euro-Betrag. Finanziert würden die Systeme durch die Bundesrepublik Deutschland. (Quelle: DPA)
15:48 Uhr | Moskau meldet wachsendes Interesse an russischen Waffen
Das Interesse an russischen Rüstungsgütern im Ausland ist nach Angaben aus Moskau auf Rekordniveau. Vizeregierungschef Denis Manturow sagte bei einem Treffen mit Präsident Wladimir Putin, bis 2022 habe der jährliche Auftragswert maximal 55 Milliarden Dollar betragen. Jetzt seien es 70 Milliarden Dollar. Manturow erklärte, besonders gefragt seien russische Flugabwehrkomplexe, Flugzeuge und Mehrfachraketenwerfer. Im Dezember hatte Manturow allerdings eingeräumt, dass Exportaufträge mit Verspätung abgearbeitet würden, weil zuerst die russische Armee versorgt werde. (Quelle: DPA)
14:39 Uhr | Merz äußert Verständnis für Indiens Gas- und Ölimport
Bundeskanzler Friedrich Merz hat Verständnis dafür geäußert, dass Indien noch russisches Gas und Öl bezieht. Merz sagte bei seinem Indien-Besuch nach einem Treffen mit Ministerpräsident Narendra Modi: "Wir sind uns in der Bewertung des Angriffskrieges Russlands gegen die Ukraine vollkommen einig". Druck auf Indien lehnte er ab. "Ich habe gleichzeitig verstanden, wie abhängig Indien auch über die letzten Jahre und Jahrzehnte von russischen Öl- und Gaslieferungen nach wie vor ist", sagt er.
Deutschland habe diese Abhängigkeit fast auf null reduzieren können. "So einfach geht das in Indien offensichtlich nicht, und ich bin der Letzte, der hier mit erhobenem Zeigefinger Besuch in anderen Ländern macht", fügt er hinzu. (Quelle: Reuters)
10:22 Uhr | US-Außenminister Rubio empfängt Wadephul zu Gespräch über Ukraine-Krieg
Inmitten intensiver Beratungen zwischen Europäern, der Ukraine und den USA über eine gemeinsame Haltung in den Verhandlungen zwischen den USA und Russland über einen Waffenstillstand in der Ukraine besucht der deutsche Außenminister Johann Wadephul die US-Hauptstadt. (Quelle: dpa)
09:45 Uhr | 35.000 Haushalte um Odessa ohne Strom
Für 35.000 Haushalte im südukrainischen Gebiet Odessa ist nach einem russischen Drohnenangriff der Strom ausgefallen. Das teilte der Stromversorger DTEK mit und sprach von einem schweren Schaden. "Die Wiederherstellung der Versorgung braucht Zeit", hieß es in der Mitteilung. In der Hafenstadt Odessa traf der Angriff ein Objekt der Infrastruktur und ein Wohnhaus, wie Bürgermeister Serhij Lyssak auf Telegram mitteilte. Zwei Menschen seien verletzt worden.
Viele ukrainische Großstädte sitzen im Dunkeln Wegen der schweren Luftangriffe der vergangenen Tage gibt es in der Hauptstadt Kiew, in Dnipro, Odessa und anderen Städten der Ukraine so gut wie keinen Strom. Deshalb fallen auch Heizung und Wasser aus. Zugleich herrscht strenger Frost von Nachttemperaturen bis minus 18 Grad. Die Lage ist für Millionen Menschen äußerst angespannt. (Quelle: dpa)
01:50 Uhr | Erneute Luftangriffe auf Kiew
Nach den schweren Angriffen auf Kiews Energieinfrastruktur am Freitag greift Russland die ukrainische Hauptstadt erneut aus der Luft an. In einem der Stadtteile sei wegen der Angriffe ein Feuer ausgebrochen, teilte der Chef der Kiewer Militärverwaltung, Timur Tkatschenko, mit. Die ukrainische Luftabwehr versuche, den Angriff abzuwehren.
Wegen der Angriffe am Freitag waren in Kiew die Strom- und Wärmeversorgung zeitweise ausgefallen – bei Temperaturen von minus zehn Grad und kälter. (Quelle: Reuters)
00:30 Uhr | Kiesewetter schlägt deutsche Beteiligung an Atom-Schutzschirm vor
Wegen der unberechenbaren Politik von US-Präsident Donald Trump und der Bedrohungen aus Russland schlägt der CDU-Außenpolitiker Roderich Kiesewetter vor, dass Deutschland sich an der Finanzierung eigener Atomwaffen beteiligen könnte. "Deutschland könnte sich an einem europäischen Schirm finanziell beteiligen, ohne die Führung zu übernehmen", sagte der CDU-Außenpolitiker Roderich Kiesewetter der "Süddeutschen Zeitung".
Angesichts der Ambitionen der französischen Rechtspopulistin Marine Le Pen, die nächste Präsidentin Frankreichs zu werden, rät Kiesewetter zu anderen Optionen, als nur auf Frankreich zu setzen. Der 2+4-Vertrag zur deutschen Einheit schließe zwar eine nationale Eigenentwicklung aus, nicht aber eine finanzielle Beteiligung an der Entwicklung mit anderen Staaten, betonte Kiesewetter. Daher sollte Deutschland eine Allianz mit anderen Staaten bilden. (Quelle: Süddeutsche Zeitung)
00:05 Uhr | Die Ereignisse gestern – 11. Januar 2026
Der von schweren russischen Drohnenangriffen verursachte Stromausfall in der Region Saporischschja wurde weitgehend behoben. Dem örtlichen Energieversorger zufolge konnte am Morgen die Stromversorgung wiederhergestellt werden. Betroffen waren demnach 382.500 Familien sowie Firmen.
In der Hauptstadt Kiew sind jedoch nach dem schweren russischen Angriff am Freitag mehr als 1.000 Wohngebäude weiterhin ohne Heizung. Die Lage bei der Energieversorgung bleibe sehr schwierig, teilte Bürgermeister Vitali Klitschko mit. Ein Raketenangriff hatte bei starkem Frost praktisch die gesamte Stadt von der Strom- und Wärmeversorgung abgeschnitten.
In der westrussischen Region Woronesch ist eine Frau nach Angaben der Behörden an den Folgen eines nächtlichen ukrainischen Drohnenangriffs ums Leben gekommen. Gouverneur Alexander Gussew teilte mit, die junge Frau sei in der Nacht auf der Intensivstation gestorben. Demnach erlitt sie Verletzungen durch auf ein Wohnhaus gefallene Drohnentrümmer.
00:00 Uhr | Ukraine-News am Montag, 12. Januar 2026
Guten Tag! In unseren Ukraine-News halten wir Sie weiterhin über die Entwicklungen im Krieg gegen die Ukraine auf dem aktuellen Stand. Alle wichtigen Nachrichten dazu erscheinen hier im Laufe des Tages.
Die Berichterstattung über den Russland-Ukraine-Krieg ist komplex. Angaben zu Kriegsverlauf, Beschuss und Opfern durch offizielle Stellen der russischen und der ukrainischen Konfliktparteien können in der aktuellen Lage nicht unmittelbar von unabhängiger Stelle überprüft werden. Es gibt eine Vielzahl von Medienvertretern vor Ort, darunter auch unabhängige Journalisten aus verschiedenen Ländern. Bei der Bewertung von Informationen sind verschiedene Quellen und eine kritische Haltung unerlässlich, um ein möglichst umfassendes Bild zu erhalten. Alles das berücksichtigt der MDR in seinen Berichten über den Russland-Ukraine-Krieg.
Haftungsausschluss: Das Urheberrecht dieses Artikels liegt bei seinem ursprünglichen Autor. Der Zweck dieses Artikels besteht in der erneuten Veröffentlichung zu ausschließlich Informationszwecken und stellt keine Anlageberatung dar. Sollten dennoch Verstöße vorliegen, nehmen Sie bitte umgehend Kontakt mit uns auf. Korrektur Oder wir werden Maßnahmen zur Löschung ergreifen. Danke